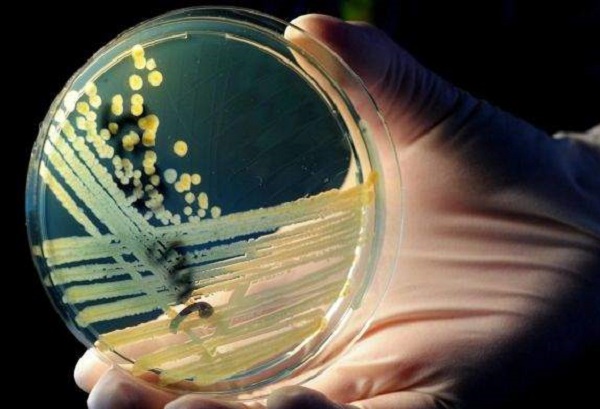
Antibiotici: un nuovo laser ha individuato i killer del farmaco

Antibiotici: un nuovo laser ha individuato i killer del farmaco
di Redazione

Incredibile scoperta che ha evidenziato quali sono i killer che persistono agli antibiotici. La rivoluzionaria identificazione dei killer degli antibiotici è stata possibile grazie a un laser a raggi X iper veloci.
Debutto del laser Xfel
Un team di 120 ricercatori hanno dato vita ad un nuovo potentissimo laser denominato Xfel. Questo laser, che è nato nella struttura del centro tedesco di ricerca sulla fisica nucleare ha dato subito i primi frutti. Gli studiosi grazie ad esso, infatti, hanno individuato quali sono i killer che resistono agli antibiotici. L'enzima che resiste alla somministrazione di questi farmaci salvavita sono stati individuati. Il laser Xfel riesce tranquillamente a proiettare all'incirca 4,5 milioni di raggi X al secondo, che consentono al ricercatore di osservare e svelare da quale struttura tridimensionale è composta una molecola. La velocità utilizzata dal laser europeo non era mai stata adottata, fin'ora, su nessun altro tipo di microscopio o apparecchio di scannerizzazione.Xfel aiuterà moltissimo la ricerca
Grande entusiasmo, ovviamente, da parte dei ricercatori che hanno messo a punto il nuovo e potentissimo laser. Come dichiarato ad Ansa, Anton Barty, che è alla guida del gruppo di studiosi e responsabile del CFEL (Center for Free-Electron Laser Science, ndr) si è detto soddisfattissimo del nuovo laser: "E' stato simile all'inaugurazione di un nuovo aeroplano. Non sai se vola finché non lo si prova!". I ricercatori si dicono molto soddisfatti della velocità del nuovo laser Xfel poiché dà la possibilità di ottenere risultati veloci su esperimenti che in passato richiedevano molte ore di lavoro. Invece, adesso, con il nuovo laser le analisi possono essere effettuate in pochi attimi.Articolo Precedente
Antonella Clerici viene ancora pagata per La Prova del Cuoco?
Articolo Successivo
Ameba mangia-cervello: morto 29enne negli Stati Uniti



